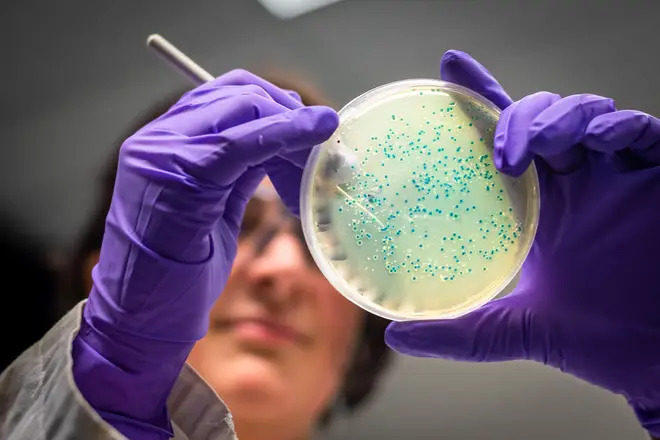

Report by
Outbreak
Salmonella Outbreak Linked to Unusual Strain Leaves Five Hospitalized
1 year ago •source lbc.co.uk
United Kingdom
A recent salmonella outbreak has resulted in five hospitalizations and 20 reported illnesses, including 13 children. The UK Health Security Agency (UKHSA) has identified the pathogen as an unusual strain known as Salmonella Saintpaul.The outbreak, which began on February 20, has affected various regions across the UK. Six cases were reported in the North West, four in the West Midlands, three in the South West, and two in the East of England. Single cases were also recorded in London, the East Midlands, the North East, and the South East. Additionally, two cases were confirmed in Northern Ireland and Wales, and one in Scotland. The patients' ages range from one to 88, with sixteen females and nine males affected.
The issue came to light when the UKHSA began investigating the sudden spike in salmonella cases. Gauri Godbole, deputy director of gastrointestinal infections at the UKHSA, stated, "UKHSA is investigating a small outbreak of Salmonella and no cases have been identified since March 2025."
Salmonella is a bacterium that can cause food poisoning, typically found in raw or undercooked meat, poultry, eggs, unpasteurised milk, and occasionally in fruits and vegetables that have been contaminated. Symptoms usually develop six to 72 hours after consuming contaminated food or water and can last four to seven days.
168
Comments
Comment